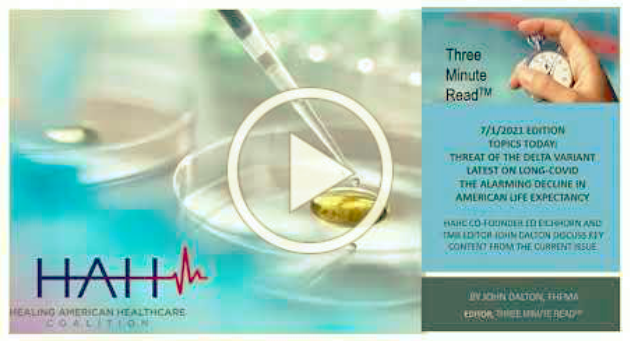
Our latest podcast is available: "COVID Options: Where We Are &amp; What's To Come" - we hope you'll tune in and feel free to share! conta.cc/3xx1eYh

Ed Eichhorn
@edeichhorn
I am the founder of the Medilink Consulting Group. I am also a co-author of our book Healing American Healthcare, A Plan to Provide Quality Care for All
ID: 176072304
http://www.healingamericanhealthcare.org 08-08-2010 13:38:04
76 Tweet
24 Followers
52 Following














I'd like to thank host Thom Clutterbuck Underwood for having me on his podcast, The Rebel Health Coach. We discussed ACA, what's ailing healthcare system today, the effects of the pandemic on healthcare, and what we can do to fix it. I hope you'll listen and share! conta.cc/3zumxtF






I hope you'll take a moment to read the new Healing American Healthcare™ blog by John J. Dalton, FHFMA, Editor of The Three Minute Read™. In it, he shares his insights about Covid-19 - has the pandemic become endemic? John Dalton #covid #pandemic conta.cc/3LqJyDM